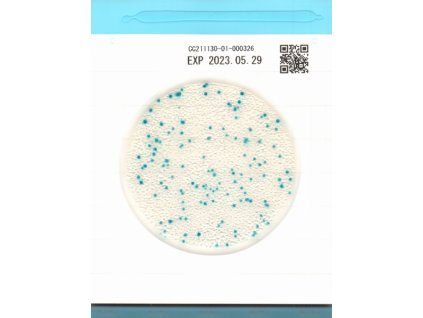
Easy Plate CC

Mikrobiologie
Řazení produktů
6 položek celkem
Výpis produktů
2 900 Kč
3 990 Kč
1 900 Kč
Ovládací prvky výpisu
6 položek celkem